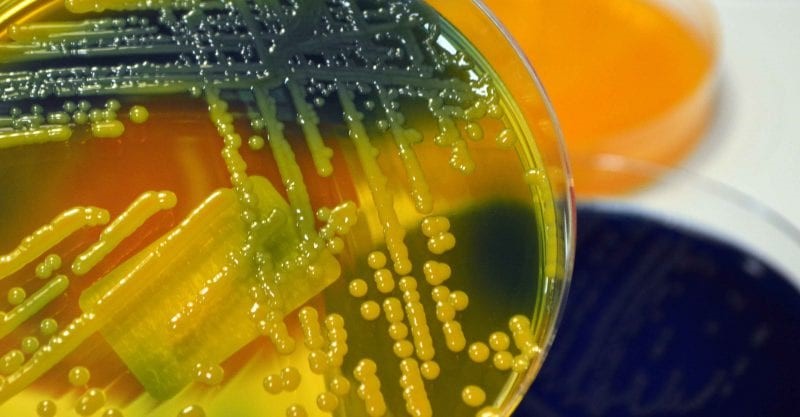
Hospital acquired infections cause more than just physical distress to patients. Interesting article on the mental health aspect of Hospital Acquired Infections
nurse.com/blog/2019/03/2…
#antibiotics #infection #health #treatment #life <a href="/liaonet/">Bill Liao ☯</a> <a href="/SOSV/">SOSV - Deep Tech for Human and Planetary Health</a> <a href="/RebelBio/">RebelBio</a>
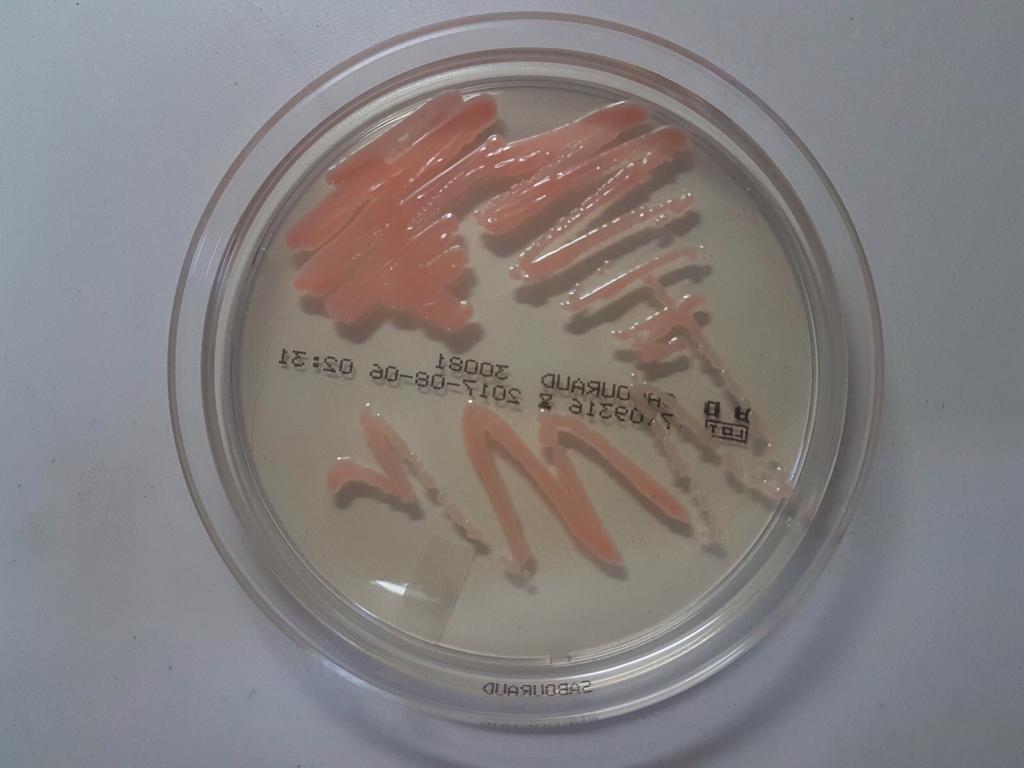
We prevent sepsis with our rapid diagnostic biosensor. Please see the last report on sepsis and what we are working on to solve.
'Alarming' one in five deaths due to sepsis
bbc.com/news/health-51………
#antibiotics #infection #health #treatment #sepsis 
<a href="/liaonet/">Bill Liao ☯</a>
<a href="/SOSV/">SOSV - Deep Tech for Human and Planetary Health</a>
<a href="/RebelBio/">RebelBio</a>

Aksense
@aksensemedical
Digitalizing infection diagnosis for enhanced patient care and safety
ID: 1132041918345633794
24-05-2019 21:53:20
40 Tweet
108 Followers
54 Following

Surgical site infections (SSI) are among the most common HAI, with over half a million SSI cases every year. This is what drives me to develop a bedside device to reduce infection diagnosis time. #antibiotics #infection #health #treatment #life Bill Liao ☯ SOSV - Deep Tech for Human and Planetary Health RebelBio


Happy Holidays and a wonderful New Year from RebelBio!! 🕎🎁🎊🥂🎄 Wishing you all great success in the year to come! #HappyFestivus SOSV - Deep Tech for Human and Planetary Health Bill Liao ☯

Hospital acquired infections cause more than just physical distress to patients. Interesting article on the mental health aspect of Hospital Acquired Infections nurse.com/blog/2019/03/2… #antibiotics #infection #health #treatment #life Bill Liao ☯ SOSV - Deep Tech for Human and Planetary Health RebelBio

Do you know that on any given day there is 98,000 patients with at least one healthcare associated infections? #antibiotics #infection #health #treatment #life Bill Liao ☯ SOSV - Deep Tech for Human and Planetary Health RebelBio


We prevent sepsis with our rapid diagnostic biosensor. Please see the last report on sepsis and what we are working on to solve. 'Alarming' one in five deaths due to sepsis bbc.com/news/health-51……… #antibiotics #infection #health #treatment #sepsis Bill Liao ☯ SOSV - Deep Tech for Human and Planetary Health RebelBio

Over 500,000 healthcare-associated infections every year are due to surgical site infections. This is one reason why it is important to reduce diagnosis time to the minimum to provide effective treatment. #antibiotics #infection #health #treatment #life Bill Liao ☯ SOSV - Deep Tech for Human and Planetary Health RebelBio


To protect yourself from harmful bacteria, wash your hands often with soap and water. This is the only recommendation in the world to prevent hospital-acquired infections in hospitals. #antibiotics #infection #health #treatment Bill Liao ☯ SOSV - Deep Tech for Human and Planetary Health RebelBio blogs.scientificamerican.com/observations/a…

Working in infection control has inspired me to develop a bedside device that can diagnose infections in minutes. This is why >>> ‘Rate of Sepsis deaths ‘much higher’ than previous estimated. medicalnewstoday.com/articles/sepsi… #antibiotics #infection #treatment Bill Liao ☯ SOSV - Deep Tech for Human and Planetary Health RebelBio

Time is critical when it comes to diagnosing infections, but current tests take up to 72 hours. Our portable bedside diagnostic device slashes this time to minutes. Bill Liao ☯ SOSV - Deep Tech for Human and Planetary Health RebelBio

This is what drives us to develop our rapid diagnose bedside device. "Experts warn that patients lives are being put at risk due to delays in giving them treatment for sepsis.” Read the Hidden Killer bbc.co.uk/news/health-48… #antibiotics #infection #health Bill Liao ☯ SOSV - Deep Tech for Human and Planetary Health RebelBio


As a profession we must do better. Shortening the diagnosis time can be a life saver. This is why we work so hard on our portable bedside diagnosis device.>>> 'Missed opportunities' bbc.co.uk/news/uk-wales-… #antibiotics #infection #health #treatment Bill Liao ☯ SOSV - Deep Tech for Human and Planetary Health RebelBio


Surgical site infections in England are the third most common Healthcare Associated Infections, but the occurrence of these infections is not dropping and is associated with extended stays and more surgical procedures. journalofhospitalinfection.com/article/S0195-… Bill Liao ☯ SOSV - Deep Tech for Human and Planetary Health RebelBio #infection



Presenting the #MedTechInnovator2020 Showcase - POC Diagnostics Panel featuring: Aksense & Inflammatix. Watch their 1-min introductory videos below, then check out The MedTech Conference for their full panel starting Thurs. Sept. 17. ow.ly/gaR650BtN5t




🚨Facing a silent crisis: AMR & hospital infections. In 2019, 1.27M deaths. Gary newman's rapid diagnostics are the answer. Read more: who.int/news-room/fact… #AKSense #AMR #HospitalInfections #HealthTech


🌟 Combatting infection risks in cancer care with innovation! Aksense's portable diagnostics biosensor enables early detection, offering early responses to prevent sepsis. 🛡️ Transforming healthcare, saving lives. #HealthTech #CancerCare #SepsisAwareness cancerresearchuk.org/about-cancer/c…
